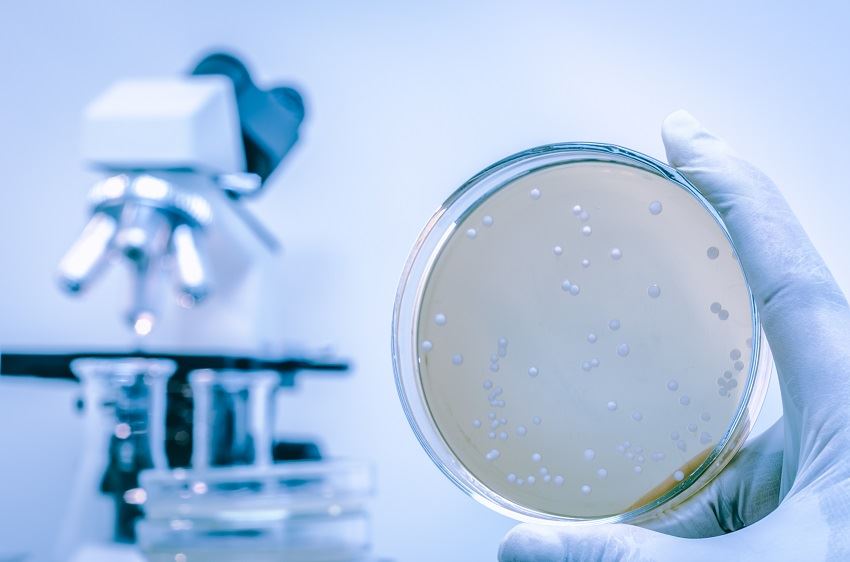

As is true of the common cold/coronaviruses, there is no evidence that COVID-19 can survive in drinking (or waste) water.
This means that, like with a common cold, a coronavirus is not known to infect mains water or water appliances like watercoolers, water filters and other drinking water appliances.
The current known sources of transmission and infection are through respiratory (breathing) and contact (touch) with the virus.
The only risk to users is the external contact surfaces and dispenser taps of the water dispenser, highlighting the importance of daily external sanitisation of water dispensers.
The importance of daily external sanitisation of water dispensers
As with the common cold, the technical structure of the COVID-19 virus means it is fragile and susceptible to disinfectant chemicals. It is important to continue with daily external cleaning of all contact surfaces using a suitable disinfectant cleaner or wipe.
If you have not already put a cleaning schedule in place, you shoud implement this immediately. You may decide to increase cleaning frequecy to reflect the usage and risk depending on your location.